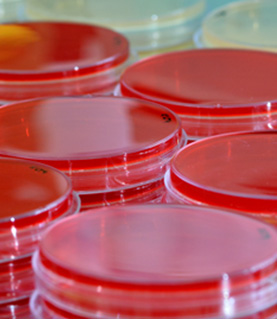

BlOcontact L21
Appareil de prélèvement microbiologique pour la validation du nettoyage des surfaces en salle propre
En complément du contrôle de l’aérobiocontamination, le contrôle de la biocontamination des surfaces est indispensable
– Applicateur de boîtes contact 55mm pour le contrôle de la biocontamination des surfaces, conforme aux recommandations des normes NF EN 17141 et NF EN ISO 18593
– Pour des prélèvements répétables et reproductibles
– Usinage du piston sur-mesure en fonction du modèle des boîtes de Pétri de diamètre 55 mm utilisées
– Signal de fin de prélèvement par vibration en plus de l’arrêt du clignotement des leds rouges
– Ressort calibré travaillant en compression limitant la force d’appui à 500 ou 600 g
– Pression d’appui uniforme sur l’ensemble de la surface du milieu gélosé
– Corps et piston en polyoxyméthylène (type DELRIN®), très résistant aux chocs et à la majorité des détergents
– Dimensions : hauteur 65 mm, diamètre 88 mm – Poids : 286 g
